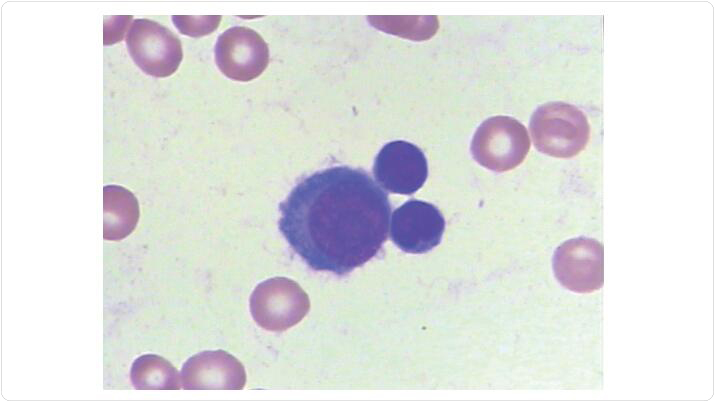

2024, Vol.18 No.6

A mechanism model of the PAK5-mediated phosphorylation of PKM2 promoting the progression of endometriosis. Courtesy of Dr. Zhenhai Yu. See pages 1054-1067 by Jiayi Lu et al. for more information)
2024, Vol.18 No.5

Difference in the nonlinear associations of (A) anemia, (B) mild anemia, (C) moderate anemia, and (D) severe anemia with BMI. (Courtesy of Drs. Liming Li, Bo Wang, Hui Liu, and Xiaoxi Liu. See pages 850-861 by Heling Bao et al. for more information.)
2024, Vol.18 No.4

A working model for synthetic lethality of BEND4 methylation and ATM inhibitor in PDAC cells. M, DNA methylation; U, DNA unmethylation; NHEJ, non-homologous end joining; DSB, double strand break. (Courtesy of Dr. Mingzhou Guo. See pages 721−734 by Yuanxin Yao et al. for more information.)
2024, Vol.18 No.3

Tregs enriched at the fracture site facilitate fracture healing by promoting the proliferation and osteogenic differentiation of mesenchymal stem cells through the high expression of Amphiregulin. (Courtesy of Dr. Chen Shi. See pages 516−537 by Tingting Wu et al. for more information.)
2024, Vol.18 No.2

Peripheral immune cells obtained from ALS patients exhibit widespread RNA hypermethylation. This dysregulated m6A modification potentially contributes to ALS pathogenesis by affecting immune cell migration in the periphery and intercellular communication within the central nervous system. (Courtesy of Drs. Xue Zhang and Liying Cui. See pages 285-302 by Di He et al. for more information.)
2024, Vol.18 No.1

TRMT2B was identified to be associated with ALS in a JALS family. (Courtesy of Drs. Junling Wang and Zhengmao Hu. See pages 68-80 by Yanling Liu et al. for more information.)
2023, Vol.17 No.6

Potential mechanism of TCM in the treatment of COVID-19. (Courtesy of Dr. Xiaolin Tong. See pages 1014-1029 by Linhua Zhao et al. for more information.)
2023, Vol.17 No.5

Genomic landscape of primary central nervous system lymphoma in Chinese patients and the mutation and high expression of TMSB4X was associated with survival of the patients (Courtesy of Dr. Wenbin Qian. See pages 889-906 by Xianggui Yuan et al. for more information.)
2023, Vol.17 No.4

Symptomatic patients during autumn/winter COVID-19 outbreaks in Chinese mainland. (A) Count of all infected cases (upper panel) and severe/critical cases (bottom panel) in Chinese mainland. (B) Pie chart of symptomatic patients with different severities treated in Shanghai Public Health Center (SHPHC). (Courtesy of Drs. Guoyu Meng, Shengyue Wang, Feng Liu, Xiaohong Fan, and Saijuan Chen. See pages 758-767 by Gang Lu et al. for more information.)
2023, Vol.17 No.3

Base editors have six potential applications in the field of biomedicine, including gene expression regulation, disease modeling, gene therapy, lineage tracing, high-throughput screening, and DNA writing. (Courtesy of Dr. Liangxue Lai. See pages 359-387 by Yanhui Liang et al. for more information.)
2023, Vol.17 No.2

Odors are crucial for mosquitoes to locate their hosts. The image is separated by an abstract side-lying human body. The upper half of human body is healthy and the ripple curves represent fewer acetophenone which makes it difficult for mosquitoes (dots) to locate the host. On the contrary, the lower half of human body is infected by flavivirus and the dense curves extended from it illustrate a large release of acetophenone which attracts great numbers of mosquitoes like a magnetic field. (Courtesy of Luoqi Chen, Hong Zou, Xiying Wei, Fei Wu, and Gong Cheng. See pages 355-357 by Hong Zhang et al. for more information.)
2023, Vol.17 No.1

Kaplan–Meier plots for survival free of MACE in all patients, and according to the predilatation result. (Courtesy of Dr. Sanna Uskela. See pages 75-84 by Sanna Uskela et al. for more information.)
2022, Vol.16 No.6

Confocal laser scanning microscopy and immunofluorescent staining was performed to examine the autophagic flux in osteosarcoma NW5 cell line. The yellow color in the merged image showed the autophagolysosomes after BafA1 treatment. (Courtesy of Drs. Hongyi Wang, Zhuochao Liu, and Qi Zhou. See pages 883-895 by Hongyi Wang et al. for more information.)
2022, Vol.16 No.5

The estimated eligibility and benefit of immune checkpoint inhibitors for different cancer types in China. (Courtesy of Dr. Chunmei Bai. See pages 773-783 by Kaili Yang et al. for more information.)
2022, Vol.16 No.4

Long-term correction of hemorrhagic diathesis in HA mice by an AAV-delivered hybrid FVIII composed of human FVIII heavy chain (hHC) and rat FVIII light chain (rLC). (Courtesy of Drs. Jianhua Mao and Xiaodong Xi. See pages 584-595 by Jianhua Mao et al. for more information.)
2022, Vol.16 No.3

Schematic of microenvironmental changes after iPSCs transplantation in the ischemic brain. (Courtesy of Drs. Mengjiao Tu and Mei Tian. See pages 429-441 by Yao Chen et al. for more information.)
2022, Vol.16 No.2

C-CAR011 is a safe and effective therapeutic option for patients with refractory DLBCL. (Courtesy of Drs. Wei Xu and Jianyong Li. See pages 285-294 by Lei Fan et al. for more information.)
2022, Vol.16 No.1

Neutralizing activity of booster vaccine-elicited sera against SARS-CoV-2 and its variants of concern. (Courtesy of Drs. Xinxin Zhang and Xiaoming Yang. See pages 93-101 by Yuntao Zhang et al. for more information.)
2021, Vol.15 No.6

Double immunostaining showed a decrease in the protein level of MCT1 (green) in Olig2-positive(red)cells induced by experimental subarachnoid hemorrhage model in the corpus callosum region, which may be one of the mechanisms of white matter damage after subarachnoid hemorrhage. (Courtesy of Dr. Gang Chen. See pages 887-902 by Xin Wu et al. for more information.)
2021, Vol.15 No.5

Schematic showing that PM2.5-induced inhibition of SIRT2 exacerbates the activation of p65 and promotes airway inflammatory injury. (Courtesy of Dr. Heng Ma. See pages 750-766 by Manling Liu et al. for more information.)
2021, Vol.15 No.4

The CT scan shows pulmonary consolidation and inflammatory hyperplasia, which is considered to be a crucial mortality risk factor in Stevens–Johnson syndrome and toxic epidermal necrolysis. (Courtesy of Dr. Jinhua Xu. See pages 585-593 by Yanhong Shou et al. for more information.)
2021, Vol.15 No.3

Comparison of average continuous glucose monitoring tracings in the subjects with obesity and overweight before and during the lifestyle interventions. (Courtesy of Dr. Weiping Jia. See pages 460-471 by Lingli Cai et al. for more information.)
2021, Vol.15 No.2

Degradation of SARS-CoV-2 receptor ACE2 by the E3 ubiquitin ligase Skp2 in lung epithelial cells. (Courtesy of Dr. Guangbiao Zhou. See pages 252-263 by Guizhen Wang et al. for more information.)
2021, Vol.15 No.1

Hypothyroidism-free survival rates for TSH-suppressed and TSH-not-suppressed patients. (Courtesy of Dr. Maura Massimino. See pages 101-107 by Maura Massimino et al. for more information.)
2020, Vol.14 No.6

PFS and OS in patients with r/r NHL after anti-CD19 CAR-T cell therapy. Kaplan–Meier estimates of OS (A) and PFS (B) in patients with NHL who achieved CR and did not achieve CR. The Kaplan–Meier estimates of OS (C) and PFS (D) in patients with bone marrow, soft tissue, lymph node, and others involvement. Patients with soft tissue involvement exhibited worse prognoses than those with BM, lymph node, or other site involvement. (Courtesy of Drs. Aibin Liang and Jie Liu. See pages 786-791 by Lili Zhou et al. for more information.)
2020, Vol.14 No.5

Dilemma of Angiotensin-converting enzyme inhibitors (ACEI) and angiotensin II receptor blockers (ARB) usage during the COVID-19 pandemic. On one hand, these medications targeting the renin-angiotensin-system (RAS) are important for maintaining optimal blood pressure in hypertensive patients (right box). On the other hand, they are hypothesized to affect the expression level of ACE2, which is the SARS-CoV-2 cellular receptor (left box). Questions remain whether ACEI/ARB should be withdrawn or substituted in context of COVID-19. Xu et al. performed a retrospective analysis in COVID-19 patients during the early pandemic and found no association between ACEI/ARB and altered clinical outcomes of COVID-19. The definitive answer still awaits further investigation. (Courtesy of Mr. Jiuyang Xu and Dr. Bin Cao. Illustration created with BioRender.com. See pages 601-612 by Jiuyang Xu et al. for more information.)
2020, Vol.14 No.4

Control method to handle individual differences. The difference between preoperative planed value calculated by the model and the actual value measured by the diagnostic device during surgery is repeatedly zeroed by convergence calculation (e.g., with a Karman filter). (Courtesy of Dr. Bo Zhang. See pages 404‒416 by Masakatsu G. Fujie and Bo Zhang for more information.)
2020, Vol.14 No.3

1p32.3 deletion (green signal) and 1q21 gain (red signal) detected through fluorescence in situ hybridization. (Courtesy of Dr. Jie Jin. See pages 327‒334 by Huanping Wang et al. for more information.)
2020, Vol.14 No.2

2019-nCoV infection-related vulnerable organs with high risk are highlighted in red; low-risk organs are indicated in gray. (Courtesy of Drs. Zeguang Han and Jie Hao. See pages 185‒192 by Xin Zou et al. for more information.)
2020, Vol.14 No.1

The detailed binding mode between C620-0696 and the BPTF bromodomain. Green dashed lines represent hydrogen bonds. (Courtesy of Drs. Qibiao Wu, Xiaojun Yao, and Liang Liu. See pages 60‒67 by Jiahui Xu et al. for more information.)
2019, Vol.13 No.6

(A) Preoperative computed tomogram (CT), (B) intraoperative clinical photograph, and (C) immediate postoperative CT of a septuagenarian male patient presenting with an unstable traumatic T8 burst fracture in the setting of ankylosing spondylitis. This patient was treated with a T6-T10 instrumented spinal fusion with robotic assistance using the ExcelsiusGPSTM robotic system. (Courtesy of Dr. Nicholas Theodore. See pages 723-729 by Bowen Jiang et al. for more information.)
2019, Vol.13 No.5
Observation under the oil microscope. CAR-T cells are attacking myeloma cells (100-fold). CAR-T cell specifically recognizes and kills tumor cells independent of MHC. (Courtesy of Drs. Aili He, Wanhong Zhao, and Wanggang Zhang. See pages 610-617 by Hongli Chen et al. for more information.)
2019, Vol.13 No.4

Fecal bacterial culture is a routine clinical examination. Hu et al. found that Candida in stool specimens significantly increased the risk of mortality and was associated with poor prognosis in patients who received haplo-HSCT. (Courtesy of Dr. Xiaodong Mo. See pages 492-503 by Lijuan Hu et al. for more information.)
2019, Vol.13 No.3

Histone-based malignant transformation, tumour heterogeneity and selection of aggressive characters. Pro-oncogenic events could lead to aberrant activation of silenced histone variants-encoding genes or histone assembly defects or histone under-dosage, leading to increased chromatin dynamics and enhanced genome reprogramming by oncogenic factors. The resulting heterogeneity would create a window of opportunity for the selection of newly reprogrammed oncogenic cells capable of surviving and disseminating. (Courtesy of Dr. Saadi Khochbin. See pages 289-297 by Tao Wang et al. for more information.)
2019, Vol.13 No.2

The efficacy of salvage interferon-α (IFN-α) treatment was investigated in patients with unsatisfactory response to minimal residual disease (MRD)-directed donor lymphocyte infusion (DLI). Patients who did not become MRD-negative at 1 month after DLI were those with unsatisfactory response and were eligible to receive salvage IFN-α treatment within 3 months of DLI. Outcomes of patients subjected to salvage IFN-α treatment after DLI were significantly better than those with persistent MRD without IFN-α treatment. (Courtesy of Dr. Xiaojun Huang. See pages 238-249 by Xiaodong Mo et al. for more information.)
2019, Vol.13 No.1

CH12 treatment led to an increase in apoptosis compared with control in HT-29-S492R EGFR xenografts. Apoptotic cells were detected using the TUNEL assay. The apoptotic index was assessed by the ratio of TUNEL-positive cells: total number of cells from six randomly selected high power fields in xenografts from six mice of each group. (Courtesy of Dr. Hua Jiang. See pages 83-93 by Qiongna Dong et al. for more information.)
2018, Vol.12 No.6

Proposed design mechanism of platelet membrane-based drug delivery systems and nanoparticle-based platelets inhibition for cancer therapy. (A) Natural or genetically engineered platelet membrane-based drug loading. (B) The blockage of cancer cells and platelets interaction by nanoparticle could realize tumor inhibition. (Courtesy of Drs. Jingyan Wei and Guangjun Nie. See pages 667-677 by Yinlong Zhang et al. for more information.)
2018, Vol.12 No.5

Placental arteries were immunohistochemically assessed (400×). Blue spots represent nuclei. Arrows indicate antibody stain. HSP20 (left) and pHSP20 (right) were located in the cytoplasm and on the cell surface of smooth muscle. (Courtesy of Dr. Dongrui Deng. See pages 542-549 by Fanfan Li et al. for more information.)
2018, Vol.12 No.4

TME components that regulate tumor progression. Schematic illustration of the major cellular and non-cellular components of TME that either promote (pink arrows) or inhibit (green “T” shapes) tumor progression. (Courtesy of Dr. Yibin Kang. See pages 426-439 by Minhong Shen and Yibin Kang for more information.)
2018, Vol.12 No.3

Intraoperative views of keel placement. The keel was kept in place to separate raw laryngeal surfaces. (Courtesy of Dr. Lei Cheng and Haitao Wu. See pages 301-306 by Jian Chen et al. for more information.)
2018, Vol.12 No.2

Lung transplantation is a treatment option for patients with end-stage BOS after HSCT. (A, B) One patient underwent bone marrow transplant for ALL in 2003 and he received BLT due to severe BOS in 2012. Since then, he has been leading a normal, active life. (C, D) Another patient suffered from BOS two years after HSCT, and she underwent BLT in 2014. Pulmonary function improved significantly after the transplant, and maintained normal during the follow-up. (Courtesy of Dr. Jingyu Chen. See pages 224-228 by Fei Gao et al. for more information.)
2018, Vol.12 No.1

Shanghai Public Health Clinical Center (SPHCC) affiliated to Fudan University is a Class A tertiary hospital, formerly known as Shanghai Infectious Diseases Hospital. SPHCC’s predecessor was Chinese Isolation Hospital which was founded in 1914. Over the past hundred years, SPHCC has made great contributions to the management and research of infectious diseases and excellent achievements in fighting against HAV, acute gastroenteritis, SARS, H1N1, H7N9, HIV, etc. (Courtesy of Shanghai Public Health Clinical Center.)
2017, Vol.11 No.4

Chronic HIV-1 infection leads to irreversible B cell perturbations despite of effective combined antiretroviral therapy (cART). Moreover, the recall antigen responses are persistently imparied even after cART. (Courtesy of Dr. Jingjing Yan. See pages 536-547 by Jingjing Yan et al. for more information.)